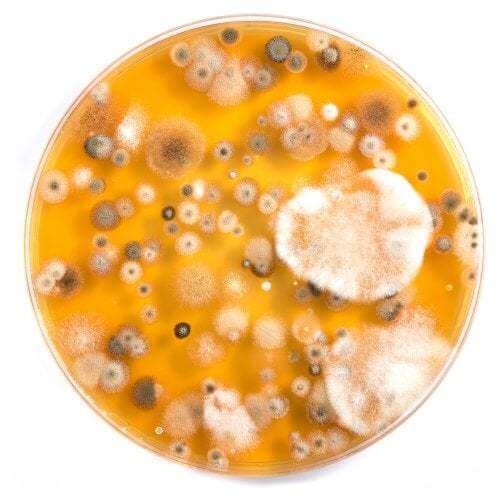
Coltura di funghi

Gli antibiotici sono efficaci contro i virus?


Scritto e verificato la biologa Olga Carbajo
Molti genitori, preoccupati per la salute dei figli, vanno dal pediatra più volte durante l’anno anche per delle infezioni alla gola. In generale, sperano nella prescrizione di antibiotici per accelerare la guarigione e rimangono delusi nel ricevere solo delle semplici indicazioni mediche. Sorge allora un dubbio: gli antibiotici sono efficaci contro i virus?
Cosa sono gli antibiotici?
Gli antibiotici hanno iniziato a essere prescritti all’inizio degli anni ’40 del secolo scorso per combattere le infezioni batteriche. Normalmente, agiscono uccidendo i batteri o impedendo loro di riprodursi, aiutando così il nostro sistema immunitario a combattere meglio le malattie. Sono quindi uno strumento di rinforzo per quei casi in cui le difese naturali del corpo sono insufficienti.
Furono scoperti per caso nel 1928 da Alexander Fleming, che osservò gli effetti di una sostanza prodotta dal fungo Penicillium notatum, la penicillina. Il suo laboratorio era quasi sempre disordinato e, quando si preparò a lanciare alcune colture batteriche, osservò che un fungo era cresciuto in esse e che i batteri ne erano stati eliminati.
La differenza tra virus e batteri
Per capire se gli antibiotici sono efficaci contro i virus, prima di tutto è necessario conoscere i microrganismi che attaccano.

I batteri sono microrganismi procariotici unicellulari, microscopici e senza nucleo. Di solito sono classificati in base alla loro forma in: noci di cocco, bacilli, vibri e spirali. Tra questi troviamo alcuni benefici per l’uomo, come il genere Lactobacilus, e altri tremendamente patogeni, come il Mycobacterium tuberculosis.
I virus invece sono agenti infettivi che richiedono un altro essere vivente per riprodursi, quindi non possono essere considerati esseri viventi. È proprio questa caratteristica degli esseri acellulari che li rende immuni agli antibiotici.
Chiaramente, entrambi gli organismi producono infezioni, ma si tratta di due tipi molto diversi di microrganismi. È a causa delle loro differenze strutturali che gli antibiotici sono efficaci contro i batteri e non contro i virus.
Gli antibiotici sono efficaci contro i virus?
La maggior parte delle infezioni infantili sono virali, quindi possiamo solo ridurre i sintomi della malattia e non trattarla con antibiotici. I virus producono malattie, in generale, più benigne dei batteri, come raffreddore, morbillo, bronchite, varicella e la maggior parte dell’angina e della gastroenterite.
Al contrario, i batteri sono la causa di malattie infettive molto più gravi, come rosolia, polmonite o otite. Tuttavia, esiste un piccolo gruppo di malattie che possono avere origine sia virale che batterica: angina, congiuntivite e meningite.
Per identificare l’origine dell’infezione, il pediatra può fare decidere di fare un test e, se non è sicuro, può chiedere al laboratorio un’analisi più approfondita per confermare la diagnosi e vedere se la prescrizione di antibiotici è la soluzione più adatta.
Effetti collaterali derivati dall’abuso di antibiotici
L’organizzazione KidsHealth avverte che l’assunzione di antibiotici per le infezioni virali è inutile contro questo tipo di malattie. Inoltre, in futuro può produrre sia effetti collaterali che resistenza contro possibili infezioni batteriche. Gli antibiotici sono efficaci contro i virus?
La somministrazione continuata di antibiotici provoca cambiamenti nel materiale genetico batterico e in altri microrganismi patogeni. Di conseguenza, detti patogeni sviluppano resistenza contro la mediazione convenzionale rendendoli immuni. Questo è noto come resistenza batterica o resistenza agli antibiotici.
Attualmente, questa resistenza si è diffusa molto e la comunità medica chiama questi microrganismi super batteri. In effetti, è richiesto l’uso di antibiotici molto potenti e pericolosi, in alcuni casi, con gravi effetti collaterali. Un esempio di questo sono le infezioni causate da pneumococchi (polmonite), meningococchi (meningite) o batteri ospedalieri.
No, gli antibiotici non sono efficaci contro i virus
Gli antibiotici non sono efficaci contro i virus perché sono forme acellulari. Combattono solo batteri e altri microrganismi patogeni. Il loro abuso crea batteri super resistenti e, inoltre, può porre fine a quelli che sono benefici per il nostro corpo.
L’Organizzazione mondiale della sanità (OMS) annovera la resistenza agli antibiotici come un problema di salute pubblica che richiede misure urgenti. A tal fine, nel 2015, l’Assemblea mondiale della sanità ha approvato un piano d’azione che intende:
- Sensibilizzare dell’opinione pubblica sull’uso improprio degli antibiotici.
- Rafforzare la ricerca e la sorveglianza.
- Ridurre l’incidenza delle infezioni.
- Ottimizzare l’uso di farmaci antimicrobici.
«Molte volte la malattia nasce dallo stesso rimedio».
-Baltasar Gracián-
Tutte le fonti citate sono state esaminate a fondo dal nostro team per garantirne la qualità, l'affidabilità, l'attualità e la validità. La bibliografia di questo articolo è stata considerata affidabile e di precisione accademica o scientifica.
- Ben-Joseph, E.P. (septiembre 2015). El peligro de abusar de los antibióticos [artículo en web especializado]Recuperado de: www.kidsheatlh.org
- Daza Pérez, D.M. (última consulta julio 2019). Resistencia microbiana a antimicrobianos . Recuperado de: Información terapéutica del sistema de Salud (vol22 nº3-1998)
- OMS. (5 febrero 2018). Resistencia a los antibiótico). Recuperado de: www.who.int/es
Questo testo è fornito solo a scopo informativo e non sostituisce la consultazione con un professionista. In caso di dubbi, consulta il tuo specialista.



